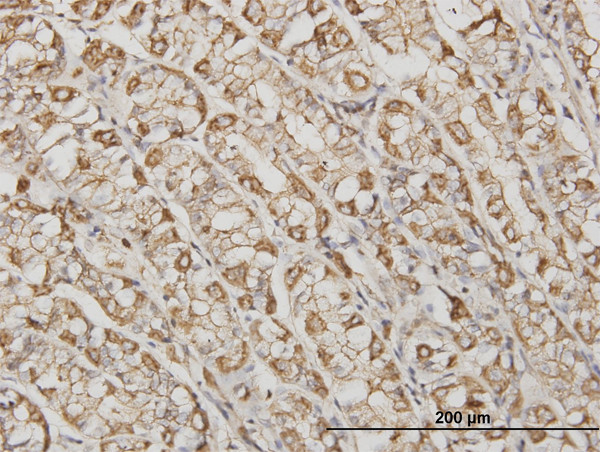
ACTB Antibody in Immunohistochemistry (Paraffin) (IHC (P))

Search
Abnova
ACTB Monoclonal Antibody (1E7)
{{$productOrderCtrl.translations['antibody.pdp.commerceCard.promotion.promotions']}}
{{$productOrderCtrl.translations['antibody.pdp.commerceCard.promotion.viewpromo']}}
{{$productOrderCtrl.translations['antibody.pdp.commerceCard.promotion.promocode']}}: {{promo.promoCode}} {{promo.promoTitle}} {{promo.promoDescription}}. {{$productOrderCtrl.translations['antibody.pdp.commerceCard.promotion.learnmore']}}
产品信息
H00000060-M03
种属反应
宿主/亚型
分类
类型
克隆号
抗原
偶联物
形式
浓度
规格
纯化类型
保存液
内含物
保存条件
运输条件
产品详细信息
Sequence of this protein is as follows: MDDDIAALVV DNGSGMCKAG FAGDDAPRAV SPSIVGRPRH QGVMVGMGQK DSYVGDEAQS KRGILTLKYP IEHGIVTNWD DMEKIWHHTF YNELRVAPEE HPVLLTEAPL NPKANREKMT QIMFETFNTP AMYVAIQAVL SLYASGRTTG IVMDSGDGVT HTVPIYEGYA LPHAILRLDL AGRDLTDYLM KILTERGYSF TTTAEREIVR DIKEKLCYVA LDFEQEMATA ASSSSLEKSY ELPDGQVITI GNERFRCPEA LFQPSFLGME SCGIHETTFN SIMKCDVDIR KDLYANTVLS GGTTMYPGIA DRMQKEITAL APSTMKIKII APPERRYSVW IGGSILASLS TFQQMWISKQ EYDESGPSIV HRKCF
靶标信息
Beta actin is one of six actin isoforms which have been identified. Beta actin is a non-muscle cytoskeletal protein in all human cell types and is involved in cell motility, structure, and integrity. There are six different actin isoforms in human. The beta isoform of actin, along with gamma actin, coexist in most cell types as components of the cyto-skeleton. Beta actins are cytoplasmic proteins ubuquitously expressed in all eukaryotic cells. Polymerization of globular actin (G-actin) leads to a structural filament (F-actin) in the form of two stranded helix. Actins are highly conserved proteins that are involved in cell motility, structure and integrity. Because beta actin is ubiquitously expressed in all eukaryotic cells, it is frequently used as a loading control for assays involving protein detection, such as Western blotting. Antibodies to beta-actin provide a specific and useful tool in studying the intracellular distribution of beta-actin and the static and dynamic aspects of the cytoskeleton.
仅用于科研。不用于诊断过程。未经明确授权不得转售。
篇参考文献 (0)
生物信息学
蛋白别名: Actin is a protein with a high degree of evolutionary conservation that undergoes polymerization to generate filaments, which subsequently assemble into interconnected networks within the cytoplasm of cells.; Actin, cytoplasmic 1; beta cytoskeletal actin; Beta-actin; cytoplasmic beta-actin; I(2)-actin; PS1TP5-binding protein 1; unnamed protein product
基因别名: ACTB; Actx; beta-actin; BKRNS; BNS; BRWS1; CSMH; DDS1; E430023M04Rik; PS1TP5BP1; THC8
UniProt ID: (Human) P60709, (Rat) P60711, (Mouse) P60710
Entrez Gene ID: (Human) 60, (Rat) 81822, (Mouse) 11461